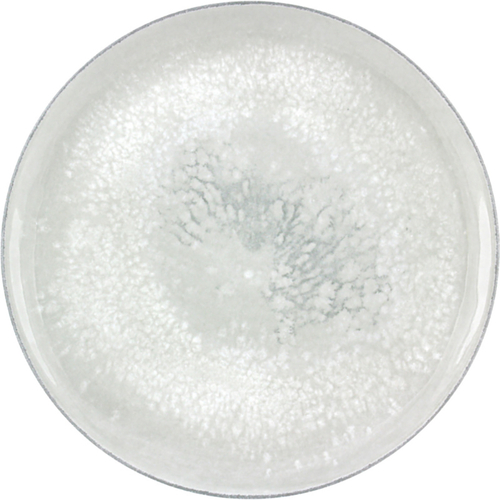
Bauscher 751228-425943 Smart 11" Coupe Plate, Salt

Shopping Cart
Total Weight:
Cart Subtotal:
Checkout using your account
This form is protected by reCAPTCHA - the Google Privacy Policy and Terms of Service apply.
Checkout as a new customer
Creating an account has many benefits:
- See order and shipping status
- Track order history
- Check out faster
Smart by Bauscher
Are you sure you would like to remove this item from the shopping cart?
This item is a part of the approved quote. Removing it will remove all quote items from the cart.